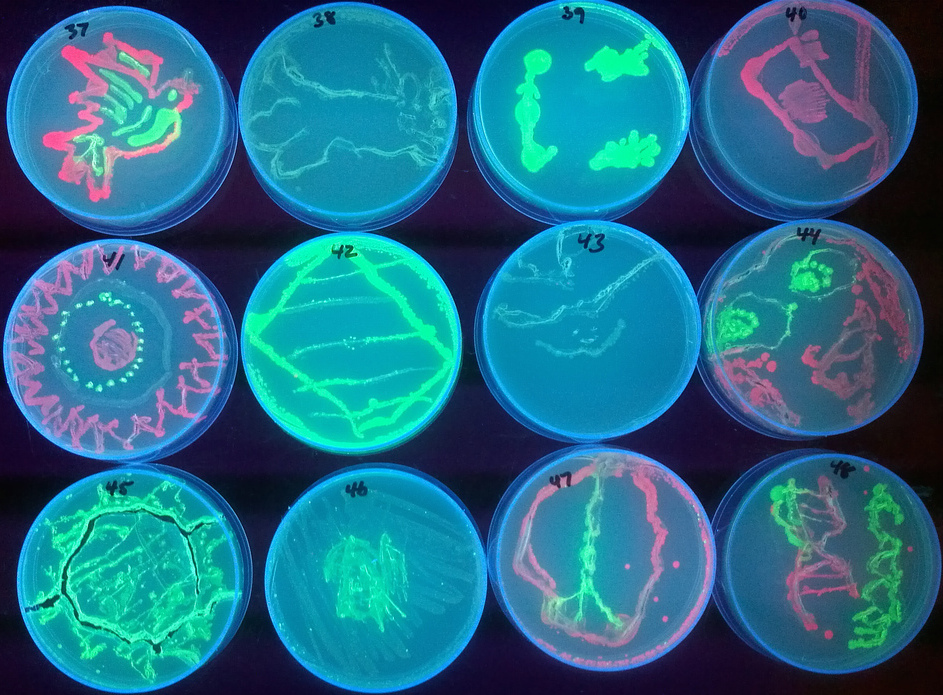

Bacteria Painting
Are you looking for the best images of Bacteria? Here you are! We collected 26+ Bacteria paintings in our online museum of paintings - PaintingValley.com.
ADVERTISEMENT
Most Downloads Size Popular
Views: 2298 Images: 26 Downloads: 3 Likes: 0

Painting Of 17 Types...
900x540 1 0
Science Saturday! Th...
943x695 1 0

Chris Hernandez Arti...
640x467 1 0

A Microbiologist Rep...
2560x1280 0 0

Artists Use Bacteria...
720x960 0 0

Bacteria Paintings! ...
480x480 0 0

Forget Paint Bacteri...
800x595 0 0

Graffiti Street Pain...
480x360 0 0

How It's Made Agar A...
3000x2400 0 0

Image Of The Day Bea...
640x500 0 0

Microbiologists Crea...
700x632 0 0

Microbiologists Recr...
700x692 0 0

Our 11 Favorite Bact...
1456x1096 0 0

Painting Portraits W...
575x575 0 0

Painting With Bacter...
704x396 0 0

Painting With Bacter...
422x406 0 0

Saatchi Art Love Bac...
770x1097 0 0

Saatchi Art Bacteria...
770x1154 0 0

Scientists Create Va...
992x745 0 0

Scientists Recreate ...
970x545 0 0

Scientists Create In...
470x548 0 0

Scientists Make Art ...
780x438 0 0

Stock Video Of 4k Gr...
852x480 0 0

This Artist Paints W...
1330x1247 0 0

Uab - Bacteria Paint...
640x646 0 0

Bacteria Painting Sa...
720x600 0 0
All rights to paintings and other images found on PaintingValley.com are owned by their respective owners (authors, artists), and the Administration of the website doesn't bear responsibility for their use. All the materials are intended for educational purposes only. If you consider that any of the materials violates your rights, and you do not want your material to be displayed on this website, please get in touch with us via "contact us" page and your copyrighted material will be immediately removed.































